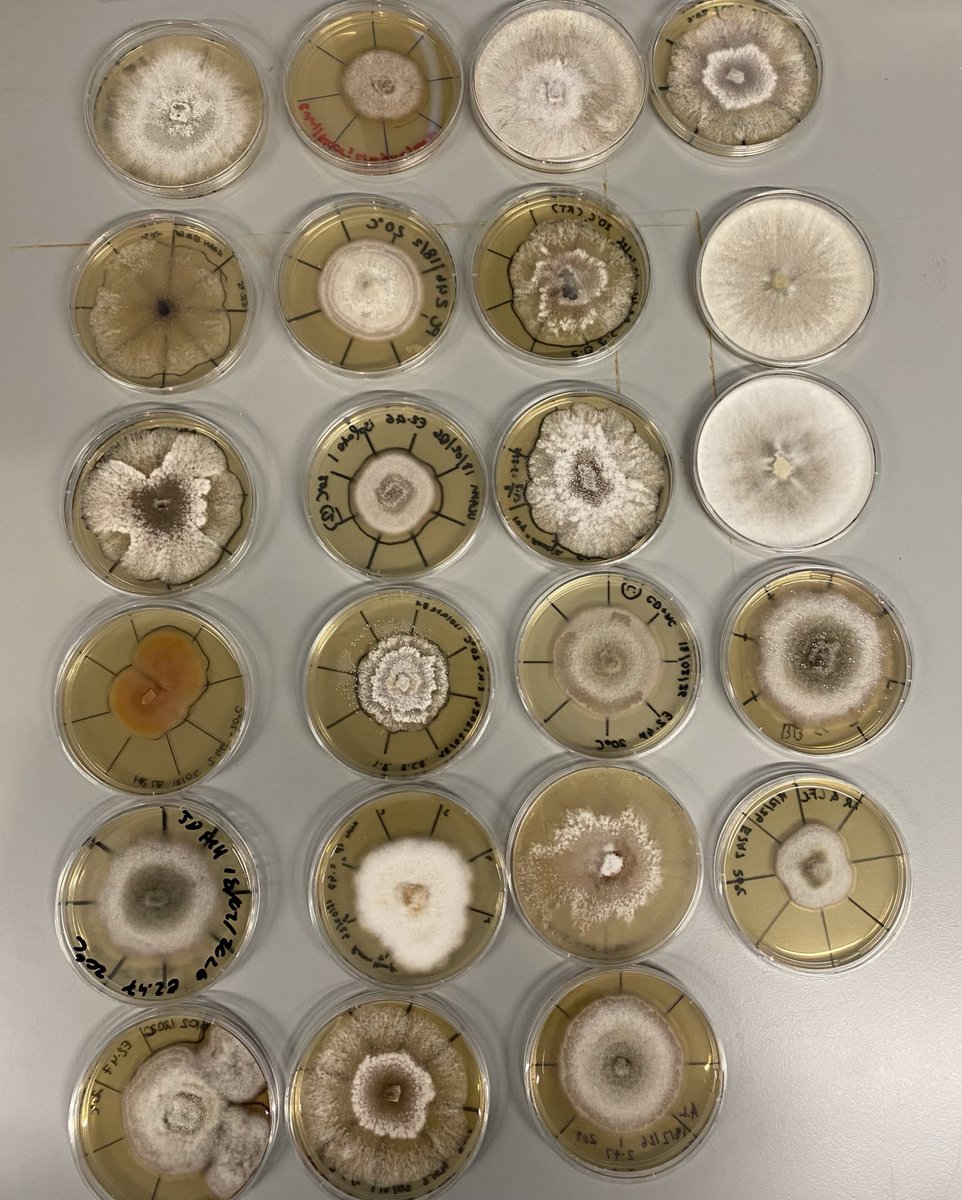
Olga Lastovetsky tweet media

Olga Lastovetsky retweetledi

Hiring Alert! My lab(labofpie.org) is looking for BS/MB-level research assistants to study fungal-bacterial competition. Come join us if you are interested!
ipmb.sinica.edu.tw/en/recruitment…
English
Olga Lastovetsky
423 posts


@OLastovetsky
Assistant Professor at University College Dublin. PI #MIntlab studying microbial interactions, fungal endobacteria, arbuscular mycorrhizal fungi, symbiosis

🧪👩🔬This Sat 14 June, 12 scientists will bring their fascinating research to Dublin city centre! #SoapboxScience Drop by South King St 1-4pm to join them in exploring topics ranging from nematodes & reptiles, to DNA & human health at this FREE event. ➡️ucd.ie/research/news/…























University College Dublin is seeking to recruit 50 early-career faculty through the Ad Astra Fellows programme: ucd.ie/adastrafellows… Applications are now open for 10 positions in the College of Science: ucd.ie/adastrafellows…




